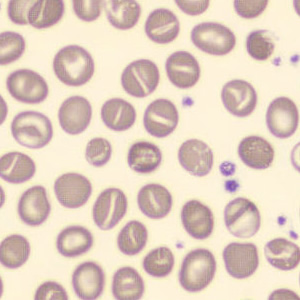
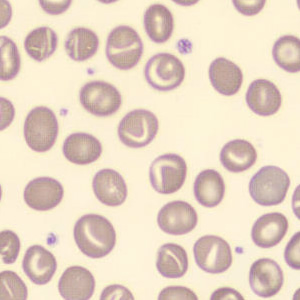
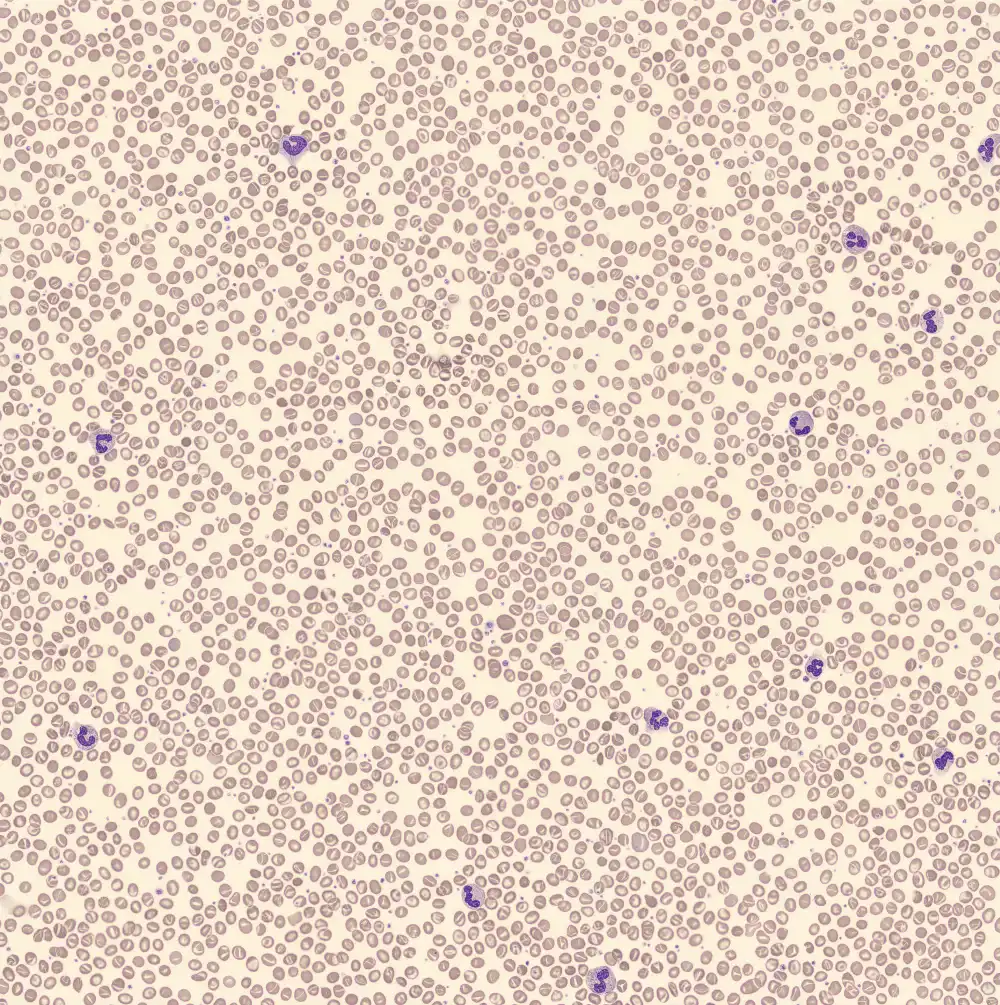

Südostasiatische Ovalozytose
Die Südostasiatische Ovalozytose (SAO) ist ein vererbbarer Erythrozytendefekt, der durch eine Mutation im SLC4A1-Gen verursacht wird. Dieses Gen kodiert für das Membranprotein Band 3, eines der Proteine, die den Erythrozyten ihre Form geben. Die roten Blutkörperchen weisen eine charakteristische ovale bis elliptische Form mit verdickten und starren Membranen auf, wodurch sie weniger formbar sind. Obwohl die meisten Träger asymptomatisch sind, kann SAE in seltenen Fällen von einer leichten Hämolyse oder Anämie begleitet sein.
Mikroskopisch sieht man Knizozyten, Ovalozyten und Stomatozyten. Die Stomatozyten können neben der klassischen Schlitzform auch eine V- oder Y-Form aufweisen.
XN Scatterplots
Erythrozyten

Periphäres Blut